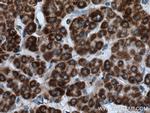
BDH1 Antibody in Immunohistochemistry (Paraffin) (IHC (P))

Search
Proteintech
BDH1 Polyclonal Antibody
{{$productOrderCtrl.translations['antibody.pdp.commerceCard.promotion.promotions']}}
{{$productOrderCtrl.translations['antibody.pdp.commerceCard.promotion.viewpromo']}}
{{$productOrderCtrl.translations['antibody.pdp.commerceCard.promotion.promocode']}}: {{promo.promoCode}} {{promo.promoTitle}} {{promo.promoDescription}}. {{$productOrderCtrl.translations['antibody.pdp.commerceCard.promotion.learnmore']}}
产品信息
15417-1-AP
种属反应
已发表种属
宿主/亚型
分类
类型
抗原
偶联物
形式
浓度
规格
纯化类型
保存液
内含物
保存条件
运输条件
产品详细信息
Immunogen sequence: MLATRLSRP LSRLPGKTLS ACDRENGARR PLLLGSTSFI PIGRRTYASA AEPVGSKAVL VTGCDSGFGF SLAKHLHSKG FLVFAGCLMK DKGHDGVKEL DSLNSDRLRT VQLNVCSSEE VEKVVEIVRS SLKDPEKGMW GLVNNAGIST FGEVEFTSLE TYKQVAEVNL WGTVRMTKSF LPLIRRAKGR VVNISSMLGR MANPARSPYC ITKFGVEAFS DCLRYEMYPL GVKVSVVEPG NFIAATSLYS PESIQAIAKK MWEELPEVVR KDYGKKYFDE KIAKMETYCS SGSTDTSPVI DAVTHALTAT TPYTRYHPMD YYWWLRMQIM THLPGAISDM IYIR (1-343 aa encoded by BC005844)
靶标信息
This gene encodes a member of the short-chain dehydrogenase/reductase gene family. The encoded protein forms a homotetrameric lipid-requiring enzyme of the mitochondrial membrane and has a specific requirement for phosphatidylcholine for optimal enzymatic activity. The encoded protein catalyzes the interconversion of acetoacetate and -3-hydroxybutyrate, the two major ketone bodies produced during fatty acid catabolism. Alternatively spliced transcript variants encoding the same protein have been described.
仅用于科研。不用于诊断过程。未经明确授权不得转售。
生物信息学
蛋白别名: (R)-3-hydroxybutyrate dehydrogenase; 3-hydroxybutyrate dehydrogenase; 3-hydroxybutyrate dehydrogenase (heart, mitochondrial); 3-hydroxybutyrate dehydrogenase, type 1; b-hydroxybutyrate dehydrogenase; b-OHBDH; BDH; D-beta-hydroxybutyrate dehydrogenase, mitochondrial; epididymis secretory sperm binding protein; MGC2723; MGC4347; MGC9788; Short chain dehydrogenase/reductase family 9C member 1
基因别名: 2310032J20Rik; AI327223; BDH; BDH1; SDR9C1
UniProt ID: (Human) Q02338, (Rat) P29147, (Mouse) Q80XN0
Entrez Gene ID: (Human) 622, (Rat) 117099, (Mouse) 71911